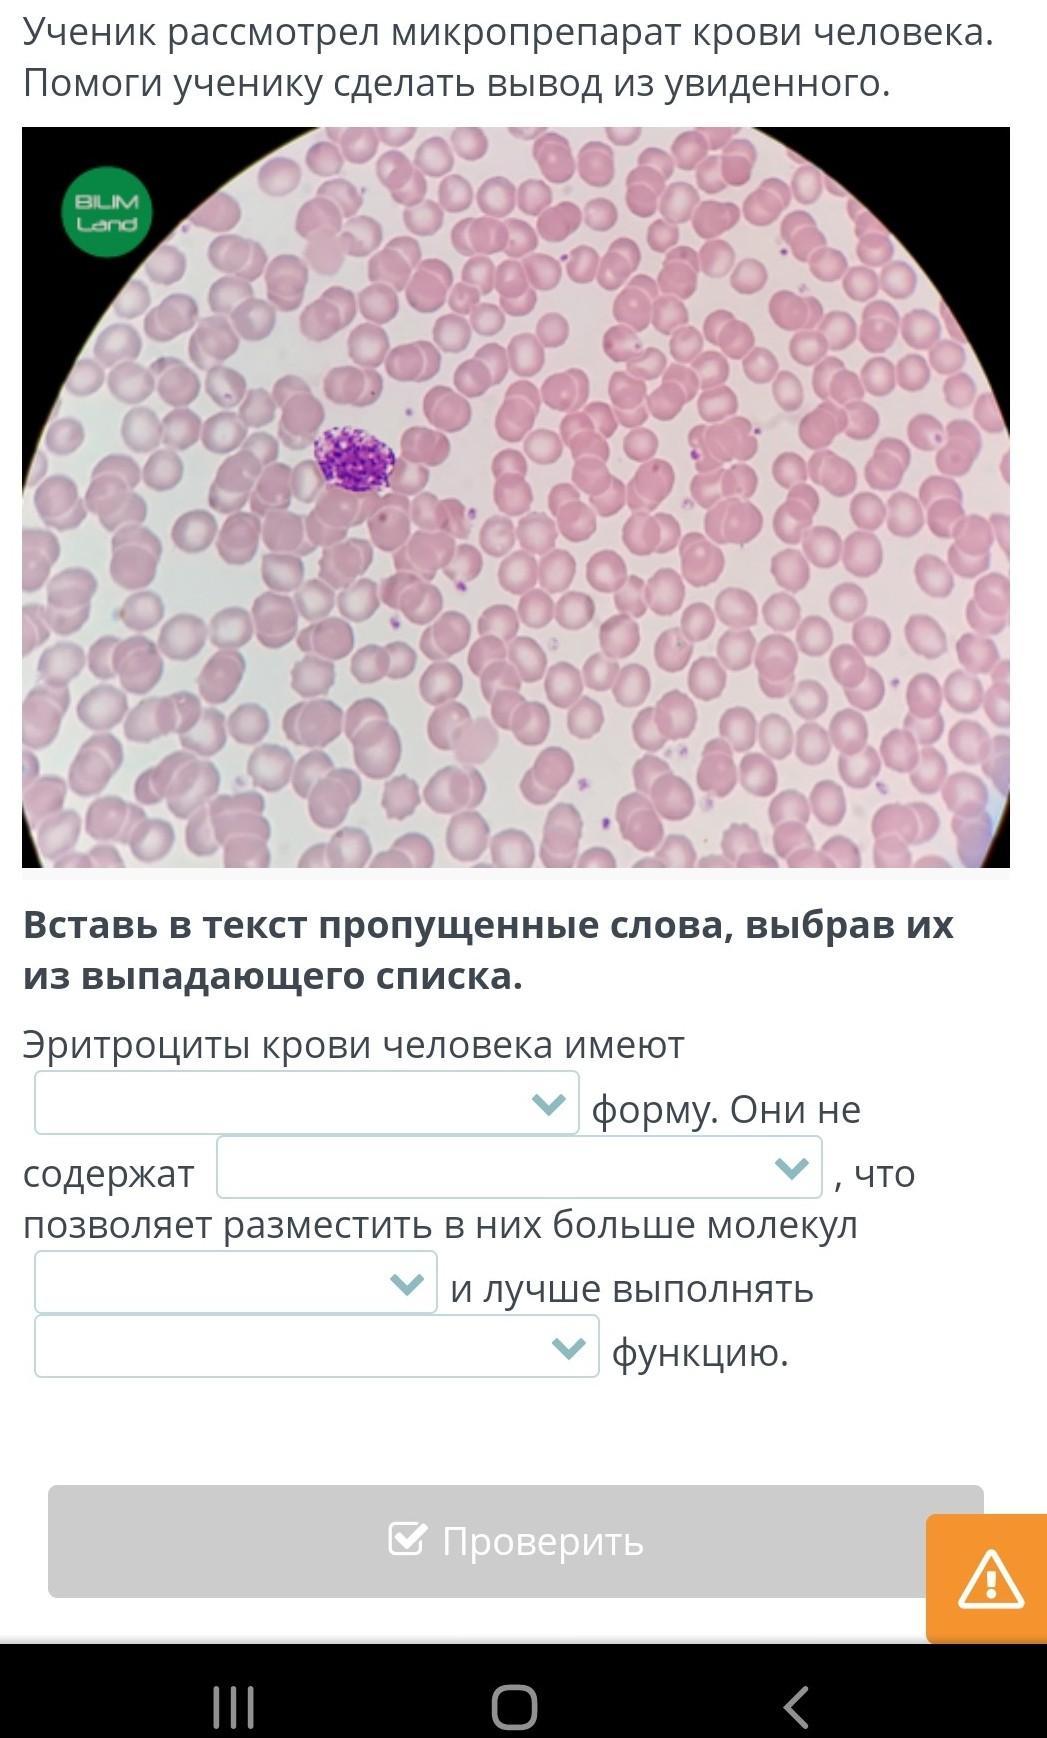

Ученик рассмотрел микропрепарат крови человека. Помоги ученику сделать вывод из увиденного.
Вставь в текст пропущенные слова, выбрав их из выпадающего списка.
Эритроциты крови человека имеют
форму. Они не содержат
, что позволяет разместить в них больше молекул
и лучше выполнять
функцию.
помогитеее
Приложения:
Ответы
Ответ дал:
32
Ответ:
Вот
Объяснение:
Приложения:

lalala23yasmina:
пасиба
Вас заинтересует
2 года назад
2 года назад
2 года назад
7 лет назад
9 лет назад